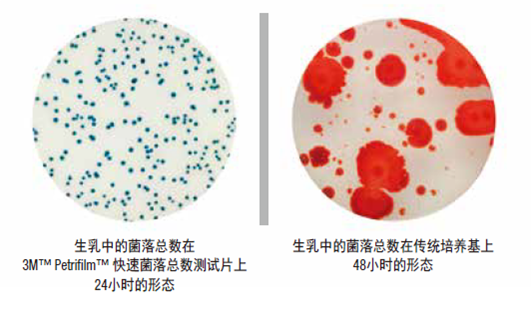
菌落總數

CSY-ATP熒光檢測儀能夠快速檢測食品中菌落總數,國內菌落總數檢測儀器有很多方法學儀器;普遍使用的儀器就是ATP熒光檢測儀,CSY-ATP熒光檢測儀基于螢火蟲發光原理,利用“熒光素酶—熒光素體系”快速檢測三磷酸腺苷(ATP)。由于所有生物活細胞中含有恒量的ATP,所以ATP含量可以清晰地表明樣品中微生物與其他生物殘余的多少,用于判斷衛生狀況。CSY-ATP熒光檢測儀用途廣泛,可用于食品、醫藥衛生、醫藥、日化、造紙、工業水處理、國防以及環保、水政、海關出入境檢疫及其他執法部門等多種行業 。
菌落總數測定是用來判定食品被細菌污染的程度及衛生質量,如果菌落總數超標嚴重,將會破壞食品的營養成分,加速食品的腐敗變質。食品與營養信息交流中心專家阮光鋒表示,菌落超標說明該產品的衛生可能有問題。消費者食用微生物超標嚴重的食品,很容易患痢疾等腸道疾病,可能引起嘔吐、腹瀉等癥狀,危害人體健康安全。
值得一提的是,菌落總數和致病菌有本質區別,菌落總數包括致病菌和有益菌,對人體有損害的主要是其中的致病菌,這些病菌會破壞腸道里正常的菌落環境,一部分可能在腸道被殺滅,一部分會留在身體里引起腹瀉、損傷肝臟等身體器官,而有益菌包括酸奶中常被提起的乳酸菌等。但菌落總數超標也意味著致病菌超標的機會增大,增加危害人體健康的幾率。
CSY-ATP熒光檢測儀技術參數:
通用國內外一體化采集拭子及分離拭子
接口技術:USB、藍牙、wifi,支持數據保存20000以上及數據上傳、藍牙打印
全自動化原裝工作軟件,無限數量的用戶身份設定,可自動判斷合格,可自動統計合格率方便用戶操作
內置可充電鋰電池,在無外接電話的情況下可工作4小時以上,且儀器具有自動節電模式功能

ATP熒光檢測儀技術參數:
☆檢測精度:1*10-16mole atp
☆檢測范圍:1-9999RLUs(可以定制1-999999)
☆檢測時間:10秒
☆重復性:≤±5%
☆采樣點設定:不低于2000個
☆存儲功能:不低于20000個檢測結果
☆接口技術:USB、藍牙、wifi
結果表述:可根據RLU值采用預置公式計算后顯示級別。
ATP熒光檢測儀|菌落總數檢測儀


